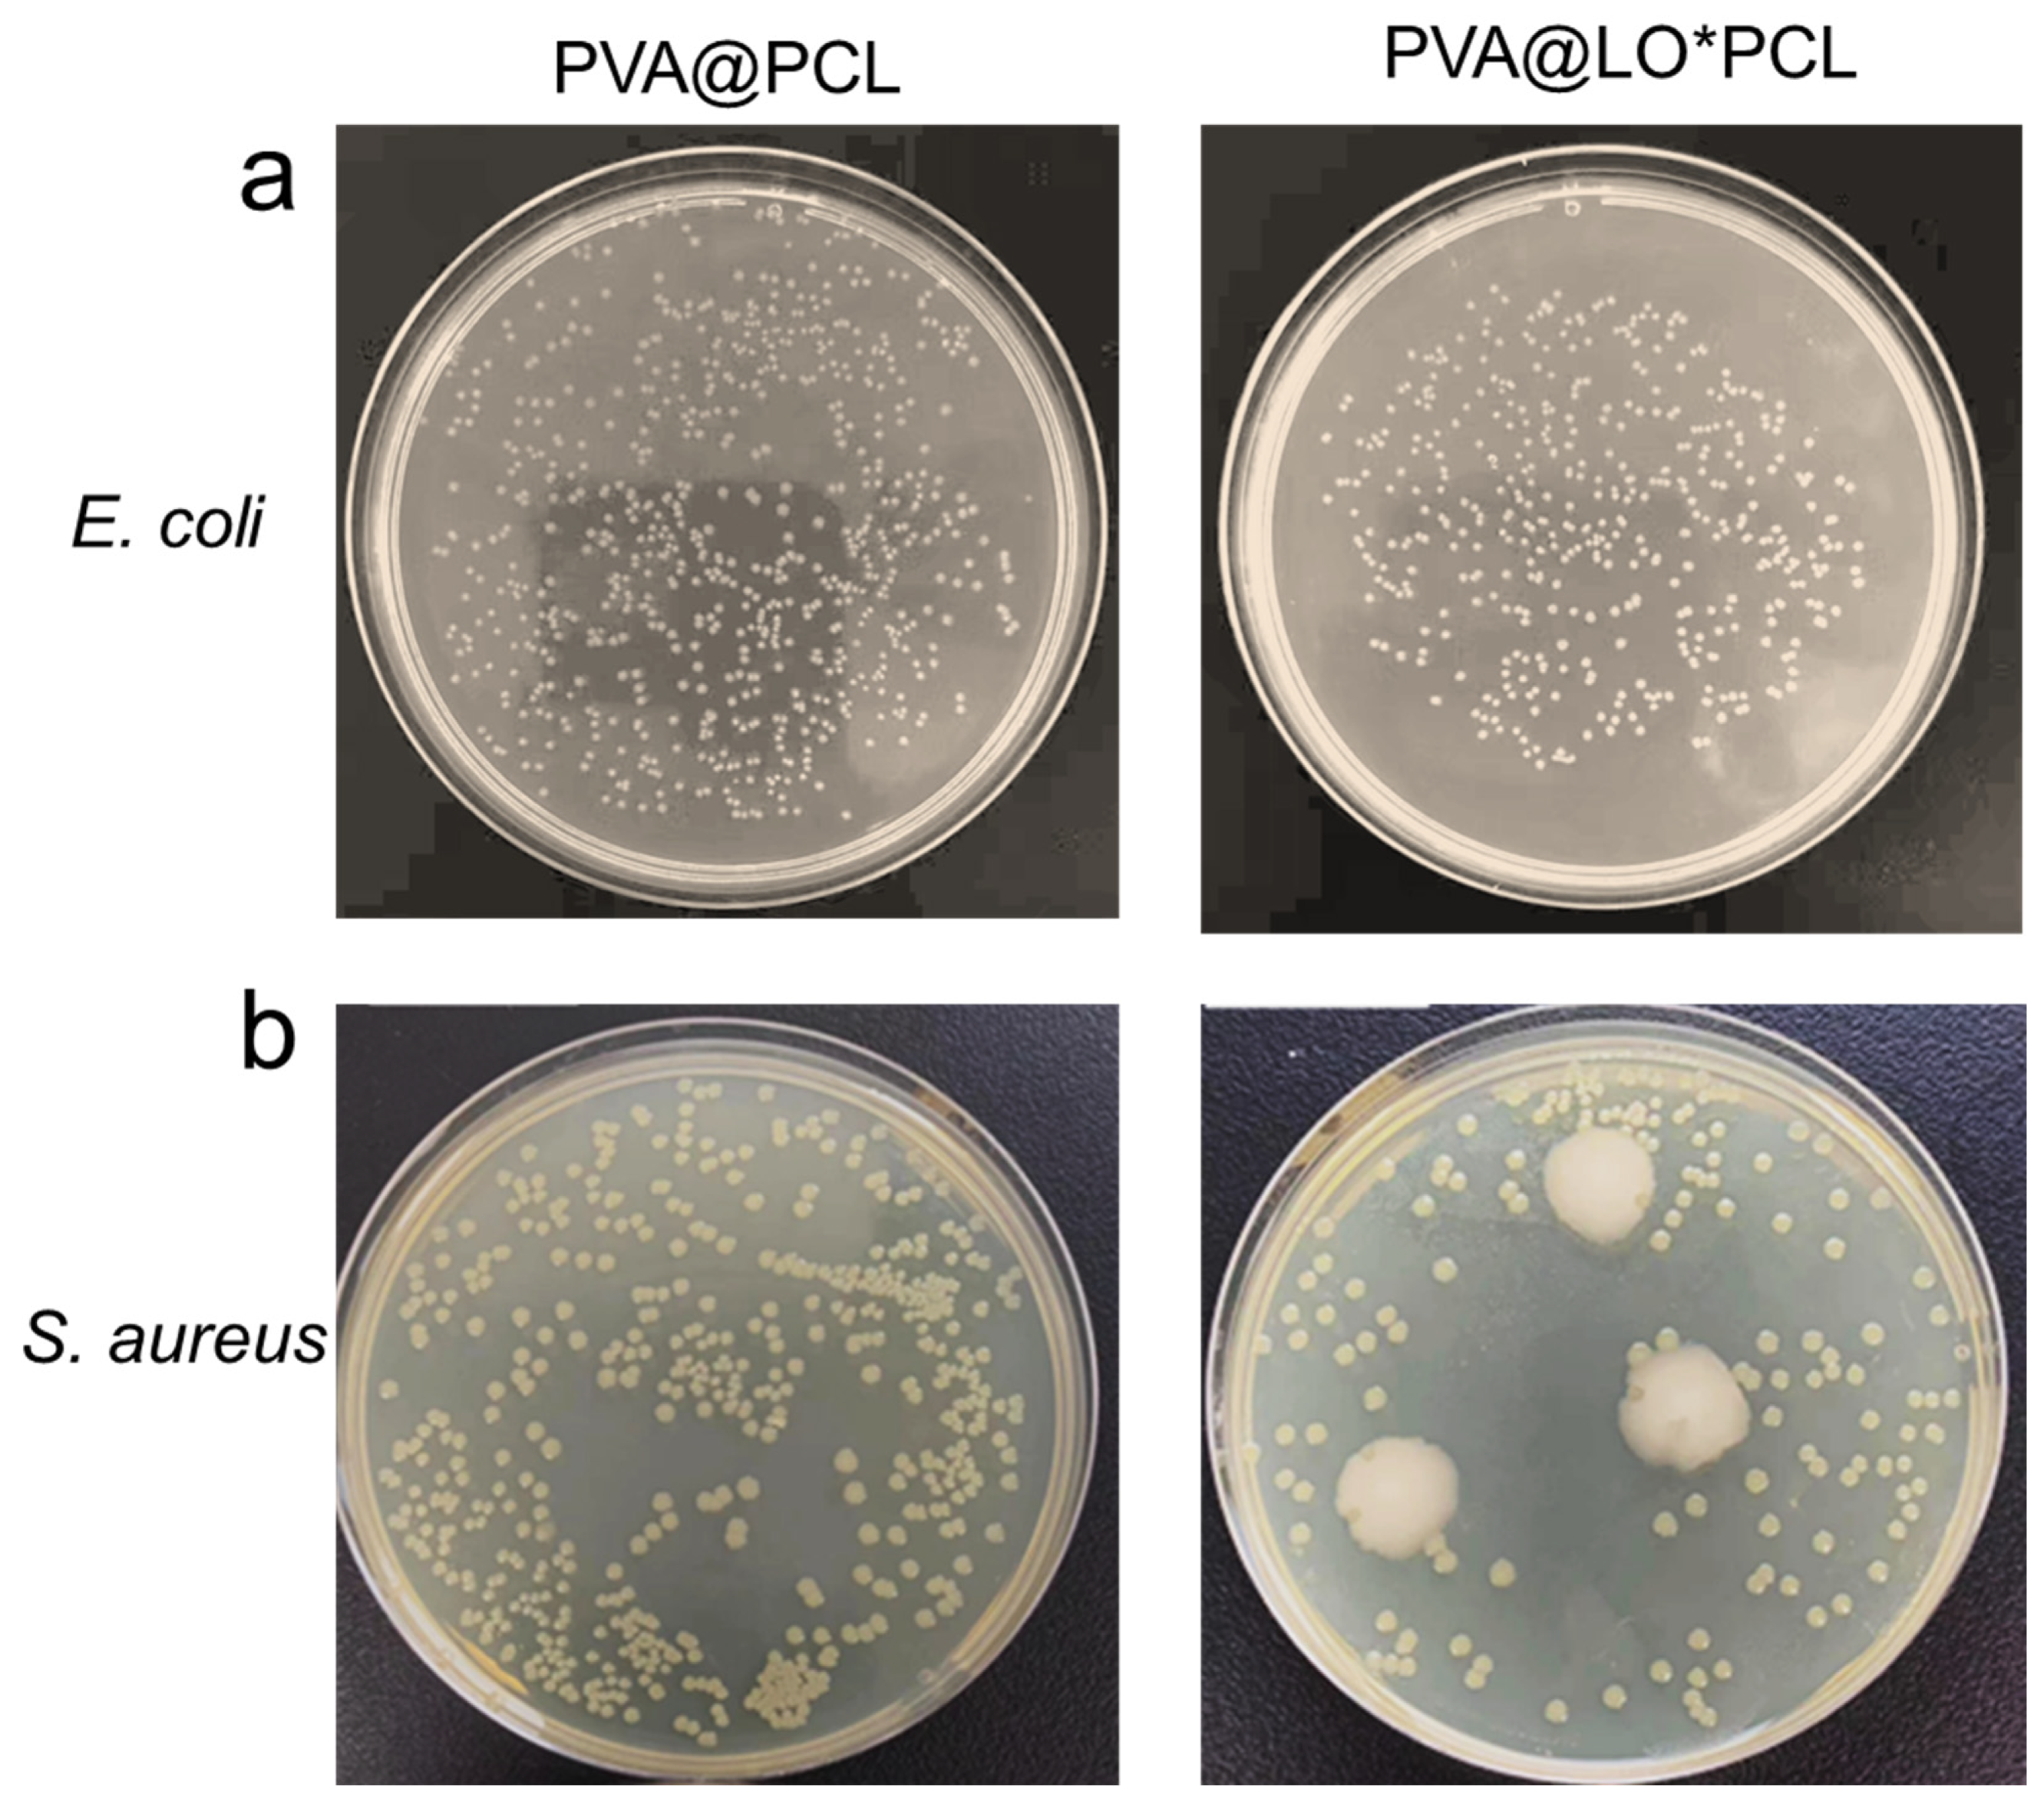

A Soothing Lavender-Scented Electrospun Fibrous Eye Mask
Abstract
1. Introduction
2. Results and Discussion
2.1. Strategy for the Preparation of the Eye Mask
2.2. Characterization of the Fibrous Membrane of the Eye Mask
2.3. Antimicrobial and Antioxidant Study
3. Materials and Methods
3.1. Materials
3.2. Preparation of Spinning Solutions and Fabrication of Nanofiber Membranes
3.3. Preparations of LO-Loaded Coaxial Nanofiber Membranes
3.4. Characterization
3.5. Antimicrobial Activity
4. Conclusions
Author Contributions
Funding
Institutional Review Board Statement
Informed Consent Statement
Data Availability Statement
Conflicts of Interest
References
- Salvioni, L.; Morelli, L.; Ochoa, E.; Labra, M.; Fiandra, L.; Palugan, L.; Prosperi, D.; Colombo, M. The emerging role of nanotechnology in skincare. Adv. Colloid Interface Sci. 2021, 293, 102437. [Google Scholar] [CrossRef] [PubMed]
- Si, Y.; Guo, C.; Xu, X.; Zhang, K.; Tan, R.; Lau, K.-T.; Hu, J. Bioinspired janus all-natural electrospinning membranes with directional water transport as ecofriendly dry facial masks. ACS Sustain. Chem. Eng. 2022, 10, 7726–7738. [Google Scholar] [CrossRef]
- Huang, L.N.; Zhong, Y.P.; Liu, D.; Wang, X.H.; Gong, C.Y.; Wen, S.; Elias, P.M.; Yang, B.; Man, M.Q. Adverse cutaneous reactions to skin care products on the face vary with age, but not with sex. Contact Dermat. 2018, 79, 365–369. [Google Scholar] [CrossRef] [PubMed]
- Horton, E.; Uter, W.; Geier, J.; Ballmer-Weber, B.; Bauer, A.; Bircher, A.; Dickel, H.; Giménez-Arnau, A.; Gonçalo, M.; John, S.M. Developing a cosmetic series: Results from the essca network, 2009–2018. Contact Dermat. 2021, 84, 82–94. [Google Scholar] [CrossRef]
- Yu, H.; Liu, M.; Lu, X.; Qu, J.; Tao, G. A cooling wound dressing for accelerating healing under sunlight. Innovation 2024, 5, 100670. [Google Scholar] [CrossRef]
- Rostami, F.; Yekrang, J.; Gholamshahbazi, N.; Ramyar, M.; Dehghanniri, P. Under-eye patch based on pva-gelatin nanocomposite nanofiber as a potential skin care product for fast delivery of the coenzyme q10 anti-aging agent: In vitro and in vivo studies. Emergent Mater. 2023, 6, 1903–1921. [Google Scholar] [CrossRef]
- Jia, C.; Wu, F.-G. Antibacterial chemodynamic therapy: Materials and strategies. BME Front. 2023, 4, 0021. [Google Scholar] [CrossRef]
- Ren, K.; Ke, X.; Zhang, M.; Ding, Y.; Wang, H.; Chen, H.; Xie, J.; Li, J. A janus adhesive hydrogel with integrated attack and defense for bacteria killing and antifouling. BME Front. 2024, 5, 0059. [Google Scholar] [CrossRef]
- Shen, X.; Cao, M.; Xing, X.; Ouyang, J.; Na, N. Advances of fluorescent DNA nanostructures in biomedical applications. Innov. Mater. 2024, 2, 100064. [Google Scholar] [CrossRef]
- Song, W.; Wen, Y.; Wang, Z.; Xu, H.; Liao, Q.; Tang, Y.; Yu, D.-G.; Kim, I. Versatile hyper-cross-linked polymers derived from waste polystyrene: Synthesis, properties, and intentional recycling. Langmuir 2024, 40, 16670–16689. [Google Scholar] [CrossRef]
- Zhang, J.; Yu, M.; Tao, S. Advanced electrospinning nanomaterials: From spinning fabrication techniques to electrochemical applications. Nano Res. 2024, 17, 7077–7116. [Google Scholar] [CrossRef]
- Tian, M.; Ma, Z.; Yang, G.-Z. Micro/nanosystems for controllable drug delivery to the brain. Innovation 2024, 5, 100548. [Google Scholar] [CrossRef] [PubMed]
- Song, W.; Tang, Y.; Qian, C.; Kim, B.J.; Liao, Y.; Yu, D.-G. Electrospinning spinneret: A bridge between the visible world and the invisible nanostructures. Innovation 2023, 4, 100381. [Google Scholar] [CrossRef] [PubMed]
- He, F.; Wang, Y.; Liu, J.; Yao, X. One-dimensional carbon based nanoreactor fabrication by electrospinning for sustainable catalysis. Exploration 2023, 3, 20220164. [Google Scholar] [CrossRef] [PubMed]
- Chen, S.; Li, J.; Zheng, L.; Huang, J.; Wang, M. Biomimicking trilayer scaffolds with controlled estradiol release for uterine tissue regeneration. Exploration 2024, 4, 20230141. [Google Scholar] [CrossRef]
- Ji, D.; Lin, Y.; Guo, X.; Ramasubramanian, B.; Wang, R.; Radacsi, N.; Jose, R.; Qin, X.; Ramakrishna, S. Electrospinning of nanofibres. Nat. Rev. Methods Primers 2024, 4, 1. [Google Scholar] [CrossRef]
- Xue, J.; Wu, T.; Dai, Y.; Xia, Y. Electrospinning and electrospun nanofibers: Methods, materials, and applications. Chem. Rev. 2019, 119, 5298–5415. [Google Scholar] [CrossRef]
- Xu, H.; Wu, Z.; Zhao, D.; Liang, H.; Yuan, H.; Wang, C. Preparation and characterization of electrospun nanofibers-based facial mask containing hyaluronic acid as a moisturizing component and huangshui polysaccharide as an antioxidant component. Int. J. Biol. Macromol. 2022, 214, 212–219. [Google Scholar] [CrossRef]
- Kang, D.; Wen, Y.; Wang, Z.; Liao, Q.; Xu, H.; Song, W.; Liao, Y.; Kim, I.-D.; Yu, D.-G. Fabrication strategies of porous nanohybrids based on electrospinning. Innov. Mater. 2024, 3, 100107. [Google Scholar]
- Yang, M.; Zhao, T.; Xia, W.; Wei, K.; Li, R.; Jiang, W.; Zhou, C.; Ben, H.; Zhang, J.; Ramakrishna, S. In-situ electrospinning with precise deposition of antioxidant nanofiber facial mask loaded with Enteromorpha prolifera polysaccharides. Int. J. Biol. Macromol. 2024, 257, 128698. [Google Scholar] [CrossRef]
- Afkhami, F.; Chen, Y.; Walsh, L.J.; Peters, O.A.; Xu, C. Application of nanomaterials in endodontics. BME Front. 2024, 5, 0043. [Google Scholar] [CrossRef] [PubMed]
- Liao, Q.; Kim, E.J.; Tang, Y.; Xu, H.; Yu, D.-G.; Song, W.; Kim, B.J. Rational design of hyper-crosslinked polymers for biomedical applications. J. Polym. Sci. 2024, 62, 1517–1535. [Google Scholar] [CrossRef]
- Yoon, J.; Yang, H.S.; Lee, B.S.; Yu, W.R. Recent progress in coaxial electrospinning: New parameters, various structures, and wide applications. Adv. Mater. 2018, 30, 1704765. [Google Scholar] [CrossRef] [PubMed]
- Zhou, J.; Wang, W.; Yang, X.; Yu, D.-G.; Liu, P. Electrospun gelatin/tea polyphenol@pullulan nanofibers for fast-dissolving antibacterial and antioxidant applications. J. Food Sci. 2024; early view. [Google Scholar] [CrossRef]
- Gong, W.; Wang, M.-L.; Liu, Y.; Yu, D.-G.; Bligh, S.W. Shell distribution of vitamin k3 within reinforced electrospun nanofibers for improved photo-antibacterial performance. Int. J. Mol. Sci. 2024, 25, 9556. [Google Scholar] [CrossRef]
- Avossa, J.; Herwig, G.; Toncelli, C.; Itel, F.; Rossi, R.M. Electrospinning based on benign solvents: Current definitions, implications and strategies. Green Chem. 2022, 24, 2347–2375. [Google Scholar] [CrossRef]
- Rahmati, M.; Mills, D.K.; Urbanska, A.M.; Saeb, M.R.; Venugopal, J.R.; Ramakrishna, S.; Mozafari, M. Electrospinning for tissue engineering applications. Prog. Mater. Sci. 2021, 117, 100721. [Google Scholar] [CrossRef]
- Liu, C.; Wang, Z.; Wei, X.; Chen, B.; Luo, Y. 3d printed hydrogel/pcl core/shell fiber scaffolds with nir-triggered drug release for cancer therapy and wound healing. Acta Biomater. 2021, 131, 314–325. [Google Scholar] [CrossRef]
- Wsoo, M.A.; Razak, S.I.A.; Bohari, S.P.M.; Shahir, S.; Salihu, R.; Kadir, M.R.A.; Nayan, N.H.M. Vitamin d3-loaded electrospun cellulose acetate/polycaprolactone nanofibers: Characterization, in-vitro drug release and cytotoxicity studies. Int. J. Biol. Macromol. 2021, 181, 82–98. [Google Scholar] [CrossRef]
- Danila, A.; Muresan, E.I.; Ibanescu, S.-A.; Popescu, A.; Danu, M.; Zaharia, C.; Türkoğlu, G.C.; Erkan, G.; Staras, A.-I. Preparation, characterization, and application of polysaccharide-based emulsions incorporated with lavender essential oil for skin-friendly cellulosic support. Int. J. Biol. Macromol. 2021, 191, 405–413. [Google Scholar] [CrossRef]
- Donelli, D.; Antonelli, M.; Bellinazzi, C.; Gensini, G.F.; Firenzuoli, F. Effects of lavender on anxiety: A systematic review and meta-analysis. Phytomedicine 2019, 65, 153099. [Google Scholar] [CrossRef] [PubMed]
- Chen, X.; Shang, S.; Yan, F.; Jiang, H.; Zhao, G.; Tian, S.; Chen, R.; Chen, D.; Dang, Y. Antioxidant activities of essential oils and their major components in scavenging free radicals, inhibiting lipid oxidation and reducing cellular oxidative stress. Molecules 2023, 28, 4559. [Google Scholar] [CrossRef] [PubMed]
- Kıvrak, Ş. Essential oil composition and antioxidant activities of eight cultivars of lavender and lavandin from western anatolia. Ind. Crops Prod. 2018, 117, 88–96. [Google Scholar] [CrossRef]
- Wang, Z.; Song, X.; Cui, Y.; Cheng, K.; Tian, X.; Dong, M.; Liu, L. Silk fibroin h-fibroin/poly(ε-caprolactone) core-shell nanofibers with enhanced mechanical property and long-term drug release. J. Colloid Interface Sci. 2021, 593, 142–151. [Google Scholar] [CrossRef]
- Wu, S.; Li, K.; Shi, W.; Cai, J. Preparation and performance evaluation of chitosan/polyvinylpyrrolidone/polyvinyl alcohol electrospun nanofiber membrane for heavy metal ions and organic pollutants removal. Int. J. Biol. Macromol. 2022, 210, 76–84. [Google Scholar] [CrossRef]
- Alharbi, H.F.; Luqman, M.; Khalil, K.A.; Elnakady, Y.A.; Abd-Elkader, O.H.; Rady, A.M.; Alharthi, N.H.; Karim, M.R. Fabrication of core-shell structured nanofibers of poly (lactic acid) and poly (vinyl alcohol) by coaxial electrospinning for tissue engineering. Eur. Polym. 2018, 98, 483–491. [Google Scholar] [CrossRef]
- Xu, C.; Ma, J.; Liu, Z.; Wang, W.; Liu, X.; Qian, S.; Chen, L.; Gu, L.; Sun, C.; Hou, J. Preparation of shell-core fiber-encapsulated lactobacillus rhamnosus 1.0320 using coaxial electrospinning. Food Chem. 2023, 402, 134253. [Google Scholar] [CrossRef]
- Lan, X.; Liu, Y.; Wang, Y.; Tian, F.; Miao, X.; Wang, H.; Tang, Y. Coaxial electrospun pva/pcl nanofibers with dual release of tea polyphenols and ε-poly (l-lysine) as antioxidant and antibacterial wound dressing materials. Int. J. Pharm. 2021, 601, 120525. [Google Scholar] [CrossRef]
- Hou, L.; Liu, X.; Ge, X.; Hu, R.; Cui, Z.; Wang, N.; Zhao, Y. Designing of anisotropic gradient surfaces for directional liquid transport: Fundamentals, construction, and applications. Innovation 2023, 4, 100508. [Google Scholar] [CrossRef]
- Adaszyńska-Skwirzyńska, M.; Zych, S.; Bucław, M.; Majewska, D.; Dzięcioł, M.; Szczerbińska, D. Evaluation of the antibacterial activity of gentamicin in combination with essential oils isolated from different cultivars and morphological parts of lavender (Lavandula angustifolia mill.) against selected bacterial strains. Molecules 2023, 28, 5781. [Google Scholar] [CrossRef]
- Park, C.H.; Park, Y.E.; Yeo, H.J.; Chun, S.W.; Baskar, T.B.; Lim, S.S.; Park, S.U. Chemical compositions of the volatile oils and antibacterial screening of solvent extract from downy lavender. Foods 2019, 8, 132. [Google Scholar] [CrossRef] [PubMed]
- Białoń, M.; Krzyśko-Łupicka, T.; Nowakowska-Bogdan, E.; Wieczorek, P.P. Chemical composition of two different lavender essential oils and their effect on facial skin microbiota. Molecules 2019, 24, 3270. [Google Scholar] [CrossRef] [PubMed]
- Xiao, Z.; Li, Q.; Niu, Y.; Zhou, X.; Liu, J.; Xu, Y.; Xu, Z. Odor-active compounds of different lavender essential oils and their correlation with sensory attributes. Ind. Crops Prod. 2017, 108, 748–755. [Google Scholar] [CrossRef]
- Truong, S.; Mudgil, P. The antibacterial effectiveness of lavender essential oil against methicillin-resistant staphylococcus aureus: A systematic review. Front. Pharmacol. 2023, 14, 1306003. [Google Scholar] [CrossRef] [PubMed]
- Wang, P.; Wang, Q.; Wu, D.; Zhang, Y.; Kang, S.; Wang, X.; Gu, J.; Wu, H.; Xu, Z.; Jiang, Q. Enhancing osteogenic bioactivities of coaxial electrospinning nano-scaffolds through incorporating iron oxide nanoparticles and icaritin for bone regeneration. Nano Res. 2024, 17, 6430–6442. [Google Scholar] [CrossRef]
- Song, W.; Zhang, M.; Huang, X.; Chen, B.; Ding, Y.; Zhang, Y.; Yu, D.G.; Kim, I. Smart l-borneol-loaded hierarchical hollow polymer nanospheres with antipollution and antibacterial capabilities. Mater. Today Chem. 2022, 26, 101252. [Google Scholar] [CrossRef]
- Luraghi, A.; Peri, F.; Moroni, L. Electrospinning for drug delivery applications: A review. J. Control. Release 2021, 334, 463–484. [Google Scholar] [CrossRef]
- Ding, Y.; Li, W.; Zhang, F.; Liu, Z.; Zanjanizadeh Ezazi, N.; Liu, D.; Santos, H.A. Electrospun fibrous architectures for drug delivery, tissue engineering and cancer therapy. Adv. Funct. Mater. 2019, 29, 1802852. [Google Scholar] [CrossRef]
- Khalf, A.; Madihally, S.V. Recent advances in multiaxial electrospinning for drug delivery. Eur. J. Pharm. Biopharm. 2017, 112, 1–17. [Google Scholar] [CrossRef]
- Wan, X.; Zhao, Y.; Li, Z.; Li, L. Emerging polymeric electrospun fibers: From structural diversity to application in flexible bioelectronics and tissue engineering. Exploration 2022, 2, 20210029. [Google Scholar] [CrossRef]
- Liu, H.; Gu, J.; Liu, Y.; Yang, L.; Wang, L.; Yu, J.; Qin, X. Reconfiguration and self-healing integrated janus electrospinning nanofiber membranes for durable seawater desalination. Nano Res. 2023, 16, 489–495. [Google Scholar] [CrossRef]
- Soo, X.Y.D.; Tan, S.Y.; Cheong, A.K.H.; Xu, J.; Liu, Z.; Loh, X.J.; Zhu, Q. Electrospun peo/peg fibers as potential flexible phase change materials for thermal energy regulation. Exploration 2024, 4, 20230016. [Google Scholar] [CrossRef] [PubMed]
- Wu, J.; Zhang, Z.; Zhou, W.; Liang, X.; Zhou, G.; Han, C.C.; Xu, S.; Liu, Y. Mechanism of a long-term controlled drug release system based on simple blended electrospun fibers. J. Control. Release 2020, 320, 337–346. [Google Scholar] [CrossRef] [PubMed]

| Samples | Tensile Stress (MPa) | Elastic Modulus (MPa) | Elongation at Break (%) |
|---|---|---|---|
| PVA | 1.55 ± 0.78 | 4.52 ± 1.16 | 31.57 ± 4.33 |
| PCL | 4.33 ± 1.45 | 10.82 ± 1.65 | 51.24 ± 3.57 |
| PVA@LO*PCL | 4.09 ± 1.27 | 9.70 ± 1.33 | 47.71 ± 4.26 |
Disclaimer/Publisher’s Note: The statements, opinions and data contained in all publications are solely those of the individual author(s) and contributor(s) and not of MDPI and/or the editor(s). MDPI and/or the editor(s) disclaim responsibility for any injury to people or property resulting from any ideas, methods, instructions or products referred to in the content. |
© 2024 by the authors. Licensee MDPI, Basel, Switzerland. This article is an open access article distributed under the terms and conditions of the Creative Commons Attribution (CC BY) license (https://creativecommons.org/licenses/by/4.0/).
Share and Cite
Kang, D.; Li, Y.; Dai, X.; Li, Z.; Cheng, K.; Song, W.; Yu, D.-G. A Soothing Lavender-Scented Electrospun Fibrous Eye Mask. Molecules 2024, 29, 5461. https://doi.org/10.3390/molecules29225461
Kang D, Li Y, Dai X, Li Z, Cheng K, Song W, Yu D-G. A Soothing Lavender-Scented Electrospun Fibrous Eye Mask. Molecules. 2024; 29(22):5461. https://doi.org/10.3390/molecules29225461
Chicago/Turabian StyleKang, Dandan, Yichong Li, Xiaowen Dai, Zixiong Li, Kai Cheng, Wenliang Song, and Deng-Guang Yu. 2024. "A Soothing Lavender-Scented Electrospun Fibrous Eye Mask" Molecules 29, no. 22: 5461. https://doi.org/10.3390/molecules29225461
APA StyleKang, D., Li, Y., Dai, X., Li, Z., Cheng, K., Song, W., & Yu, D.-G. (2024). A Soothing Lavender-Scented Electrospun Fibrous Eye Mask. Molecules, 29(22), 5461. https://doi.org/10.3390/molecules29225461

